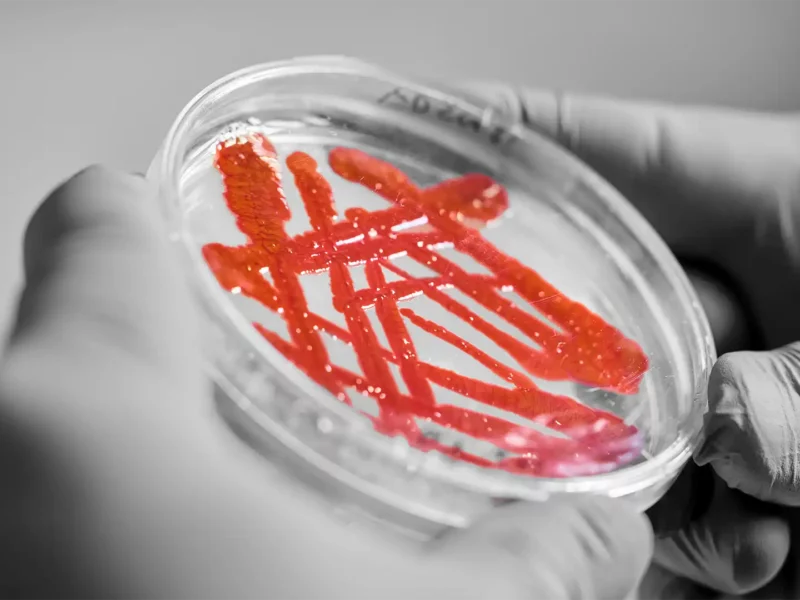
Nahaufnahme zweier behandschuhter Hände mit einer Petrischale, darauf rote Streichlinien einer Kultur.

Zu den Leistungen des nach DIN EN ISO/IEC 17025 akkreditierten Laborbereichs Biologische Prüfungen gehören die Prüfung der Wirksamkeit von Holzschutzmitteln und anderen Bioziden, die Bestimmung die Beständigkeit von Materialien gegen Mikroorganismen, z. B. der biologischen Dauerhaftigkeit von Holz und Holzwerkstoffen, Dämmstoffen und Beschichtungsmaterialien, sowie die Prüfung der mikrobiellen Belastung von Material- und Luftproben.
Die biologischen Prüfungen werden im Labor oder auf dem Freilandprüffeld durchgeführt, ggf. nach Vorbeanspruchung durch künstliche oder natürliche Bewitterung, Auswaschung bzw. im Windkanal.
Die Diagnostik von Mikroorganismen umfasst die Bestimmung von Schadorganismen mit mikrobiologischen, mikroskopischen und molekularbiologischen Diagnostikmethoden und die Ermittlung der mikrobiologischen (hygienischen) Belastung von Materialien, Oberflächen bzw. der Innenraumluft.